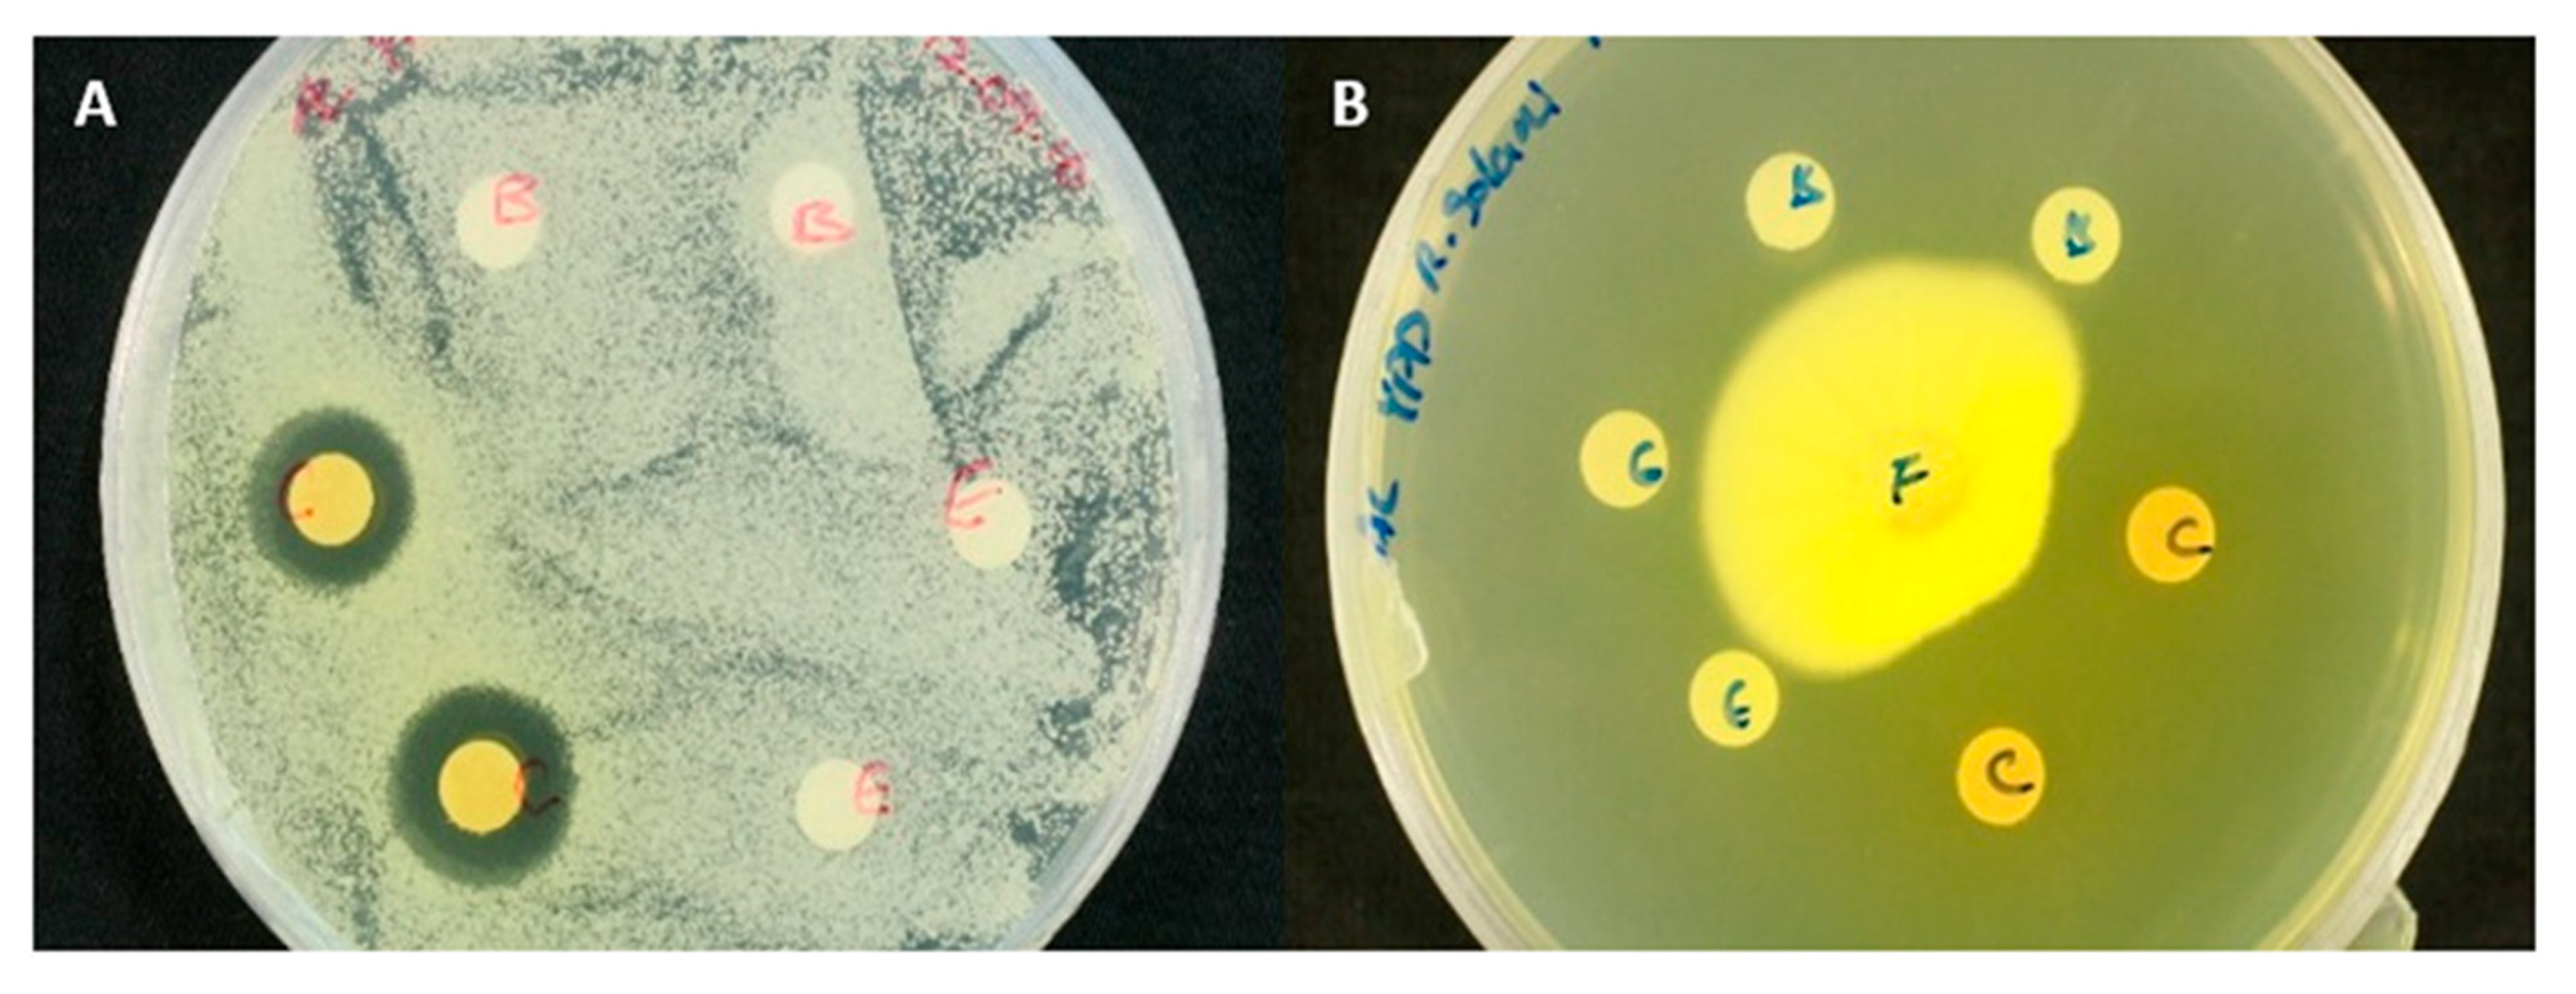
Molecules 25 05997 g003 Molecules 25 05997 g003

Epipyrone A, a Broad-Spectrum Antifungal Compound Produced by Epicoccum nigrum ICMP 19927
Abstract
1. Introduction
2. Results
2.1. Purification, Chemical Properties and Antifungal Activity
2.2. Chemical Structure Characterisation
2.3. Minimum Inhibitory Concentrations (MICs) of Disalt Epipyrone A
3. Discussion
4. Materials and Methods
4.1. Microbial Strains
4.2. Production, Extraction and Isolation of Antifungal Compounds
4.2.1. Solid-Phase Extraction (SPE)
4.2.2. Semi-Preparative Reverse-Phase HPLC
4.2.3. Column Chromatography
4.3. Structure Elucidation
4.3.1. Ultra-Performance Liquid Chromatography–High-Resolution Mass Spectrometry (UPLC–MS)
4.3.2. Nuclear Magnetic Resonance Analysis (NMR)
4.3.3. Ultraviolet-Visible (UV–Vis)
4.4. Stability Tests
4.5. Antimicrobial Activity Assays
4.5.1. Agar Diffusion Assays
4.5.2. Spore Germination Assay
4.5.3. Minimal Inhibitory Concentrations (MICs)
Supplementary Materials
Author Contributions
Funding
Acknowledgments
Conflicts of Interest
References
- Schol-Schwarz, M.B. The genus Epicoccum Link. Trans. Br. Mycol. Soc. 1959, 42, 149–173. [Google Scholar] [CrossRef]
- Arenal, F.; Platas, G.; Martín, J.; Salazar, O.; Peláez, F. Evaluation of different PCR-based DNA fingerprinting techniques for assessing the genetic variability of isolates of the fungus Epicoccum nigrum. J. Appl. Microbiol. 1999, 87, 898–906. [Google Scholar] [CrossRef]
- Peng, J.; Jiao, J.; Li, J.; Wang, W.; Gu, Q.; Zhu, T.; Li, D. Pyronepolyene C-glucosides with NF-ĸB inhibitory and anti-influenza A viral (H1N1) activities from the sponge-associated fungus Epicoccum sp. JJY40. Bioorg. Med. Chem. Lett. 2012, 22, 3188–3190. [Google Scholar] [CrossRef] [PubMed]
- Naumann, C.W. Epicoccum purpurascens und die bedingungen fur seine pigmentbildung. Hedwigia 1912, 51, 135. [Google Scholar]
- Baute, M.A.; Deffieux, G.; Baute, R.; Neveu, A. New antibiotics from fungus Epicoccum nigrum. I. Fermentation, isolation and antibacterial properties. J. Antibiot. 1978, 31, 1099–1101. [Google Scholar] [CrossRef]
- Bell, P.J.L.; Karuso, P. Epicocconone, a novel fluorescent compound from the fungus Epicoccum nigrum. J. Am. Chem. Soc. 2003, 125, 9304–9305. [Google Scholar] [CrossRef]
- El Amrani, M.; Lai, D.; Debbab, A.; Aly, A.H.; Siems, K.; Seidel, C.; Schnekenburger, M.; Gaigneaux, A.; Diederich, M.; Feger, D.; et al. Protein kinase and HDAC inhibitors from the endophytic fungus Epicoccum nigrum. J. Nat. Prod. 2014, 77, 49–56. [Google Scholar] [CrossRef]
- Wangun, H.V.K.; Dahse, H.M.; Hertweck, C. Epicoccamides B–D, glycosylated tetramic acid derivatives from an Epicoccum sp. associated with the tree fungus Pholiota squarrosa. J. Nat. Prod. 2007, 70, 1800–1803. [Google Scholar] [CrossRef]
- Zhou, T.; Reeleder, R.D. Application of Epicoccum purpurascens spores to control white mold of snap bean. Plant Dis. 1989, 73, 639–642. [Google Scholar] [CrossRef]
- Peng, G.; Sutton, J.C. Evaluation of microorganisms for biocontrol of Botrytis cinerea in strawberry. Can. J. Plant Pathol. 1991, 13, 247–257. [Google Scholar] [CrossRef]
- Larena, I.; Torres, R.; De Cal, A.; Liñán, M.; Melgarejo, P.; Domenichini, P.; Bellinic, A.; Mandrind, J.F.; Lichoud, J.; de Eribee, X.O.; et al. Biological control of postharvest brown rot (Monilinia spp.) of peaches by field applications of Epicoccum nigrum. Biol. Control 2005, 32, 305–310. [Google Scholar] [CrossRef]
- Alcock, A.; Elmer, P.; Marsden, R.; Parry, F. Inhibition of Botrytis cinerea by epirodin: A secondary metabolite from New Zealand isolates of Epicoccum nigrum. J. Phytopathol. 2015, 163, 841–852. [Google Scholar] [CrossRef]
- Burge, W.R.; Buckley, L.J.; Sullivan, J.D.; McGrattan, C.J.; Ikawa, M. Isolation and biological activity of the pigments of the mold Epicoccum nigrum. J. Agric. Food Chem. 1976, 24, 555–559. [Google Scholar] [CrossRef] [PubMed]
- Brown, A.E.; Finlay, R.; Ward, J.S. Antifungal compounds produced by Epicoccum purpurascens against soil-borne plant pathogenic fungi. Soil Biol. Biochem. 1987, 19, 657–664. [Google Scholar] [CrossRef]
- Zhang, Y.; Liu, S.; Che, Y.; Liu, X. Epicoccins A–D, epipolythiodioxopiperazines from a Cordyceps-colonizing isolate of Epicoccum nigrum. J. Nat. Prod. 2007, 70, 1522–1525. [Google Scholar] [CrossRef]
- Ikawa, M.; McGratten, C.; Burge, W.; Iannitelli, R.; Uebel, J.; Noguchi, T. Epirodin, a polyene antibiotic from mold Epicoccum nigrum. J. Antibiot. 1978, 31, 159–160. [Google Scholar] [CrossRef]
- Wright, A.D.; Osterhage, C.; König, G.M. Epicoccamide, a novel secondary metabolite from a jellyfish-derived culture of Epicoccum purpurascens. Org. Biomol. Chem. 2003, 1, 507–510. [Google Scholar] [CrossRef]
- Frederick, C.B.; Bentley, M.D.; Shive, W. Structure of triornicin, a new siderophore. Biochemistry 1981, 20, 2436–2438. [Google Scholar] [CrossRef]
- Gribanovski-Sassu, O.; Foppen, F.H. The carotenoids of the fungus Epicoccum nigrum. Phytochemistry 1967, 7, 1605–1612. [Google Scholar] [CrossRef]
- Kimura, J.; Furui, M.; Kanda, M.; Sugiyama, M. Telomerase Inhibitor. J.P. Patent 2002047281A, 12 February 2002. [Google Scholar]
- Shu, Y.Z.; Ye, Q.; Li, H.; Kadow, K.F.; Hussain, R.A.; Huang, S.; Gustavson, D.R.; Lowe, S.E.; Chang, L.-P.; Pimik, D.M.; et al. Orevactaene, a novel binding inhibitor of HIV-1 rev protein to rev response element (RRE) from Epicoccum nigrum WC47880. Bioorg. Med. Chem. Lett. 1997, 7, 2295–2298. [Google Scholar] [CrossRef]
- Preindl, J.; Schulthoff, S.; Wirtz, C.; Lingnau, J.; Fürstner, A. Polyunsaturated C-glycosidic 4-hydroxy-2-pyrone derivatives: Total synthesis shows that putative orevactaene is likely identical with epipyrone A. Angew. Chem. Int. Ed. 2017, 56, 7525–7530. [Google Scholar] [CrossRef]
- Reibarkh, M.; Wyche, T.P.; Saurí, J.; Bugni, T.S.; Martin, G.E.; Williamson, R.T. Structure elucidation of uniformly 13C labeled small molecule natural products. Magn. Reson. Chem. 2015, 53, 996–1002. [Google Scholar] [CrossRef]
- Kwon, Y.; Park, S.; Shin, J.; Oh, D.C. Application of 13C-labeling and 13C–13C COSY NMR experiments in the structure determination of a microbial natural product. Arch. Pharm. Res. 2014, 37, 967–971. [Google Scholar] [CrossRef]
- Poulton, G.A.; Cyr, T.D.; McMullan, E.E. Pyrones IV. Phacidin, a fungal growth inhibitor from Potebniamyces balsamicola Smerlis var. boycei Funk. Can. J. Chem. 1979, 57, 1451–1455. [Google Scholar] [CrossRef]
- Arenal, F.; Platas, G.; Pelaez, F. Taxonomic reconsideration of Epicoccum nigrum and Phoma epicoccina based on DNA sequences and morphological observations. Mycotaxon 2004, 89, 465–471. [Google Scholar]
- Calvo, A.; Wilson, J.; Bok, J.; Keller, N. Relationship between secondary metabolism and fungal development. Microbiol. Mol. Biol. Rev. 2002, 66, 447–459. [Google Scholar] [CrossRef]
- Garcia-Estrada, C.; Dominguez-Santos, R.; Kosalkova, K.; Martin, J. Transcription factors controlling primary and secondary metabolism in filamentous fungi: The β-lactam paradigm. Fermentation. 2018, 4, 47. [Google Scholar] [CrossRef]
- Yang, H.; Tong, J.; Lee, C.; Ha, S.; Eom, S.; Im, Y. Structural mechanism of ergosterol regulation by fungal sterol transcription factor Upc2. Nat. Commun. 2015, 6, 6129. [Google Scholar] [CrossRef]
- Cione, A.P.P.; Liberale, M.J.; da Silva, P.M. Development and validation of an HPLC method for stability evaluation of nystatin. Braz. J. Pharm. Sci. 2010, 46, 305–310. [Google Scholar] [CrossRef]
- Madden, K.S.; Mosa, F.A.; Whiting, A. Non-isoprenoid polyene natural products-structures and synthetic strategies. Org. Biomol. Chem. 2014, 12, 7877–7899. [Google Scholar] [CrossRef]
- Kim, H.J.; Han, C.-Y.; Park, J.-S.; Oh, S.-H.; Kang, S.-H.; Choi, S.S.; Kim, J.-M.; Kwak, J.-H.; Kim, E.-S. Nystatin-like Pseudonocardia polyene B1, a novel disaccharide-containing antifungal heptaene antibiotic. Sci. Rep. 2018, 8, 13584. [Google Scholar] [CrossRef]
- Carrillo-Munoz, A.; Giusiano, G.; Ezkurra, P.A.; Quindós, G. Antifungal agents: Mode of action in yeast cells. Rev. Esp. Quimioter. 2006, 19, 130–139. [Google Scholar]
- Park, H.B.; Yang, H.O.; Lee, K.R.; Kwon, H.C. Gombapyrones E and F, new α-pyrone polyenes produced by Streptomyces sp. KMC-002. Molecules 2011, 16, 3519–3529. [Google Scholar] [CrossRef]
- Vicente, F.; Basilio, A.; Cabello, A.; Pelaz, F. Microbial natural products as a source of antifungals. Clin. Microbiol. Infect. 2003, 9, 15–32. [Google Scholar] [CrossRef]
- Vengurlekar, S.; Sharma, R.; Trivedi, P. Efficacy of some natural compounds as antifungal agents. Pharmacogn. Rev. 2012, 6, 91–99. [Google Scholar] [CrossRef]
- Perfect, J.R. The antifungal pipeline: A reality check. Nat. Rev. Drug Discov. 2017, 16, 603–616. [Google Scholar] [CrossRef]
- Denning, D.W. Echinocandins: A new class of antifungal. J. Antimicrob. Chem. 2002, 49, 889–891. [Google Scholar] [CrossRef]
- François, I.E.J.A.; Aerts, A.M.; Cammue, B.P.A.; Thevissen, K. Currently used antimycotics: Spectrum, mode of action and resistance occurrence. Curr. Drug Targets 2005, 6, 895–907. [Google Scholar] [CrossRef]
- Eschenauer, G.; Depestel, D.D.; Carver, P.L. Comparison of echinocandin antifungals. Ther. Clin. Risk Manag. 2007, 3, 71–97. [Google Scholar] [CrossRef]
- Thirsk, C.; Whiting, A. Polyene natural products. J. Chem. Soc. Perkin Trans. 2002, 1, 999–1023. [Google Scholar] [CrossRef]
- Fokin, M.; Fleetwood, D.; Weir, B.S.; Villas-Boas, S.G. Genome sequence of the saprophytic ascomycete Epicoccum nigrum strain ICMP 19927, isolated from New Zealand. Genome Announc. 2017, 5, e00557-17. [Google Scholar] [CrossRef]
- Verduyn, C.; Postma, E.; Scheffers, W.A.; van Dijken, J.P. Effect of benzoic acid on metabolic fluxes in yeasts. Yeast 1992, 8, 501–517. [Google Scholar] [CrossRef]
- Arendrup, M.C.; Guinea, J.; Cuenca-Estrella, M.; Meletiadis, J.; Mouton, J.W.; Lagrou, K.; Howard, S.J. Reference method for broth dilution antifungal susceptibility testing of filamentous fungi. Clin. Microbiol. Infect. 2015, 14, 982–984. [Google Scholar]

| Condition | Specific Condition | Initial Absorbance (428 nm) | Final Absorbance (428 nm) * |
|---|---|---|---|
| pH stability | 3 | 1.46 | 1.45 |
| 5 | 1.67 | 1.67 | |
| 7 | 2.05 | 2.05 | |
| 8 | 2.09 | 2.08 | |
| 10 | 2.09 | 2.09 | |
| Stability to light | Milli-Q H2O | 2.05 | 1.82 |
| Methanol | 2.04 | 2.04 | |
| Ethanol 5% v/v in H2O | 2.04 | 2.04 | |
| Stability to temperature | −20 °C in water | 2.08 | 2.07 |
| −20 °C in methanol | 2.05 | 2.06 | |
| 4 °C in water | 2.08 | 2.06 | |
| 4 °C in methanol | 2.05 | 2.03 | |
| 60 °C in water (60 min) | 2.08 | 2.06 | |
| 60 °C in methanol (60 min) | 2.05 | 2.04 | |
| 100 °C in water (60 min) | 2.08 | 2.07 | |
| Stability to microwave radiation | Domestic microwave (5 min, 1000 W) | 2.05 | 2.04 |
| Species | Strain Designation | Maintenance | * Growth Inhibition |
|---|---|---|---|
| Alternaria alternata | ICMP 1099-96 | PDA at 25 °C | + |
| Aspergillus fumigatus | SVB-F18 | PDA at 28 °C | + |
| Aspergillus niger | ICMP 17511 | PDA at 25 °C | + |
| Aspergillus oryzae | ICMP 1281 | PDA at 25 °C | + |
| Botrytis cinera | ICMP 16621 | PDA at 25 °C | + |
| Candida albicans | MEN | YPD at 28 °C | + |
| Enterococcus faecalis | NCTC 775 | NA at 28 °C | − |
| Epidermophyton floccosum | SVB-F16 | PDA at 28 °C | + |
| Escherichia coli | W3110 | NA at 28 °C | − |
| Magnaporthe grisea | SVF-F2 | PDA at 25 °C | + |
| Micrococcus luteus | SVB-B32 | NA at 28 °C | − |
| Microsporum gypseum | NZRM2242 | PDA at 28 °C | + |
| Mucor fresen | PDD 42019 | PDA at 25 °C | + |
| Mycosphaerella graminicola | PDD 12257 | PDA at 25 °C | + |
| Phomopsis viticola | ICMP 16419 | PDA at 25 °C | + |
| Pseudomonas aeruginosa | SVB-B9 | NA at 28 °C | − |
| Rhizoctonia solani | ICMP 11620 | PDA at 25 °C | + |
| Rhizopus stolonifer | ICMP 13555 | PDA at 25 °C | + |
| Saccharomyces cerevisiae | CEN.PK113.7D | YPD at 28 °C | + |
| Sclerotinia sclerotiorum | ICMP 13844 | PDA at 25 °C | + |
| Staphylococcus aureus | ATCC 29213 | NA at 28 °C | − |
| Trycophyton rubrum | NZRM3251 | PDA at 28 °C | + |
| Venturia inaequalis | PDD 32452 | PDA at 25 °C | + |
| Epipyrone A [3] | Compound 1 | Compound 2 | ||||
|---|---|---|---|---|---|---|
| No. | δC, type a | δH (J in Hz) b | δC, type c | δH (J in Hz) d | δC, type c | δH (J in Hz) d |
| 1 | 164.9 | - | 169.4 | - | 166.1 | - |
| 2 | 100.4 | - | 98.9 | - | 102.1 | - |
| 3 | 169.1 | - | 181.8 | - | 170.4 | - |
| 4 | 100.9 | 6.08, s | 110.2 | 5.81, s | 102.3 | 6.10, s |
| 5 | 159.4 | - | 158.4 | - | 160.7 | - |
| 6 | 121.1 | 6.18, d (14.8) | 124.1 | 6.11, d (15) | 122.4 | 6.20, d (14.8) |
| 7 | 136.8 | 7.12, dd (14.8) | 135.0 | 7.06, dd (15, 10) | 138.1 | 7.14, dd (14.8) |
| 8 | 130.9 | 6.43, m | 132.4 | 6.43, m | 130.1 | 6.43, m |
| 9 | 139.3 | 6.62, dd | 138.6 | 6.55, dd | 140.6 | 6.64, dd |
| 10 | 132.7 | 6.32, m | 133.2 | 6.35, m | 134.0 | 6.32, m |
| 11 | 132.2 | 6.41, m | 133.1 | 6.41, m | 133.5 | 6.41, m |
| 12 | 135.7 | 6.47, m | 137.1 | 6.45, m | 137.0 | 6.47, m |
| 13 | 128.8 | 6.39, m | 128.6 | 6.35, m | 132.3 | 6.39, m |
| 14 | 136.3 | 6.34, m | 136.7 | 6.35, m | 137.6 | 6.34, m |
| 15 | 139.0 | 6.44, m | 141.5 | 6.35, m | 140.3 | 6.44, m |
| 16 | 135.3 | - | 141.1 | - | 136.6 | - |
| 17 | 130.1 | 6.13, s | 134.3 | 6.01, s | 132.2 | 6.12, s |
| 18 | 127.7 | - | 134.4 | - | 131.3 | - |
| 19 | 147.8 | 5.61, d (10.5) | 140.4 | 5.12, d (9.7) | 149.0 | 5.60, d (10.5) |
| 20 | 31.8 | 3.03, m | 33.1 | 2.73–2.80, m | 33.1 | 3.02, m |
| 21 | 44.5 | 1.12, 1.35, m | 46.3 | 1.32–1.39, m | 45.8 | 1.12, 1.35, m |
| 22 | 32.5 | 1.32, m | 33.5 | 1.05, 1.31, m | 33.8 | 1.32, m |
| 23 | 29.9 | 1.16, 1.33, m | 31.1 | 1.13, 1.30, m | 31.2 | 1.16, 1.33, m |
| 24 | 10.4 | 0.87, t (7.6) | 11.6 | 0.87, t (7.8) | 11.6 | 0.86, t (7.5) |
| 25 | 18.2 | 0.85, d (6.0) | 20.0 | 0.87, d (6.8) | 19.5 | 0.85, d (6.0) |
| 26 | 20.4 | 1.02, d (6.6) | 22.0 | 1.01, d (6.7) | 21.7 | 1.02, d (6.6) |
| 27 | 170.7 | - | 178.3 | - | 172.0 | - |
| 28 | 12.5 | 1.88, s | 13.3 | 1.97, s | 13.7 | 1.87, s |
| 29 | 75.0 | 4.55, d (9.3) | 77.2 | 4.53, d (9.6) | 76.3 | 4.54, d (9.7) |
| 30 | 68.9 | 4.21, t (9.9) | 69.4 | 4.40, dd (9.6) | 70.1 | 4.20, t (9.7) |
| 31 | 75.2 | 3.53, dd (2.7, 9.3) | 77.5 | 3.47, dd (9.6, 3.4) | 76.5 | 3.52, dd (2.7, 9.3) |
| 32 | 69.9 | 3.93, d (2.7) | 71.9 | 3.85, d (3.4) | 71.2 | 3.93, d (2.7) |
| 33 | 79.5 | 3.62, m | 80.5 | 3.58–3.61, m | 80.8 | 3.60, m |
| 34 | 61.5 | 3.72–3.76, m | 62.8 | 3.72–3.68, m | 62.8 | 3.72–3.74, m |
| Organism | MIC (mg.mL−1) | |
|---|---|---|
| Filamentous fungi | Aspergillus oryzae | 2.00 |
| Sclerotinia sclerotiorum | 0.20 | |
| Yeasts | Saccharomyces cerevisiae | 0.03 |
| Candida albicans | 0.04 |
Sample Availability: Samples of the compounds are not available from the authors. |
Publisher’s Note: MDPI stays neutral with regard to jurisdictional claims in published maps and institutional affiliations. |
© 2020 by the authors. Licensee MDPI, Basel, Switzerland. This article is an open access article distributed under the terms and conditions of the Creative Commons Attribution (CC BY) license (http://creativecommons.org/licenses/by/4.0/).
Share and Cite
Lee, A.J.; Cadelis, M.M.; Kim, S.H.; Swift, S.; Copp, B.R.; Villas-Boas, S.G. Epipyrone A, a Broad-Spectrum Antifungal Compound Produced by Epicoccum nigrum ICMP 19927. Molecules 2020, 25, 5997. https://doi.org/10.3390/molecules25245997
Lee AJ, Cadelis MM, Kim SH, Swift S, Copp BR, Villas-Boas SG. Epipyrone A, a Broad-Spectrum Antifungal Compound Produced by Epicoccum nigrum ICMP 19927. Molecules. 2020; 25(24):5997. https://doi.org/10.3390/molecules25245997
Chicago/Turabian StyleLee, Alex J., Melissa M. Cadelis, Sang H. Kim, Simon Swift, Brent R. Copp, and Silas G. Villas-Boas. 2020. "Epipyrone A, a Broad-Spectrum Antifungal Compound Produced by Epicoccum nigrum ICMP 19927" Molecules 25, no. 24: 5997. https://doi.org/10.3390/molecules25245997
APA StyleLee, A. J., Cadelis, M. M., Kim, S. H., Swift, S., Copp, B. R., & Villas-Boas, S. G. (2020). Epipyrone A, a Broad-Spectrum Antifungal Compound Produced by Epicoccum nigrum ICMP 19927. Molecules, 25(24), 5997. https://doi.org/10.3390/molecules25245997

